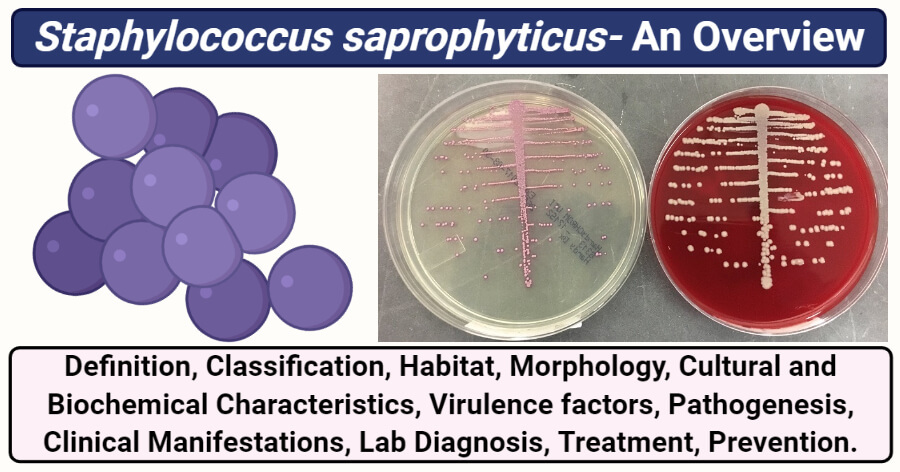

Características gerais dos Staphylococcus: (7)

- Cocos Gram +
- Imóveis
- Em cacho, não esporulados;
- Catalase +;
- Pouco exigentes, ubíquos;
- Meios com 10% NaCl (o que lhes permite por exemplo viverm bem em suores)

Colonizadores da pele e mucosa
Quais são os Staphyloccocus coagulase positivos? E coagulase negativos?

Coagulase positivos:
- S. aureus;
Coagulase negativos:
- S. epidermis,
- S. saprophyticus,
- S. haemolyticus,
- S. lugdunensis.
Nota: Há mais de coagulase positivos, mas faz-se esta referência por serem os principais.

Qual a espécie de Staphylococcus resistente à novobiocina?
S. saprophyticus.
Qual o meio seletivo para Staphylococcus?
Manitol salgado; Chapmann.
Qual o Staphylococcus que fermenta o manitol?
S. aureus - o meio fica amarelo (senão era cor de rosa),
Quais são os fatores de virulência do S. aureus?

Fatores de adesão ao hospedeiro:
- Clumping factor
- Coagulase
Fatores de evasão da defesa do hospedeiro:
Proteção de fagocitose:
- proteína A
- coagulase
Inativação de moléculas antibacterianas: proteases, lipases, catalase;
Superantigénio:
- Enterotoxinas;
- TSST1
- toxina gamma, PVL.
Factores de invasão dos tecidos do hospedeiro

Patologia associada a S. epidermis
Associada a dispositivos médicos:
- Endocardite protésica;
- Bacteriemia associada a cateter vascular;
- Peritonite por diálise peritoneal contínua ambulatória;
- Infeção de próteses articulares. (pensar: Pele->Próteses)

Patologia associada a S. saprophyticus
Infeção urinária em mulher jovem, sexualmente ativa.
Patologia associada a S. aureus
- Infecções supurativas - bactéria no local, com produção de conteudo purulento
- Doença mediada por exotoxinas - não tem a bactéria no local
As enterotoxinas, como a enteroxina A, causam enteroentrites rápidas (6h), mas porque não tem la a bactéria, tambem são de resolução mais rápida.
Síndroma da pele escaldada é causada pelas toxinas exfoliativas.

Quais são as principais resistências associadas ao S. aureus?
MRSA:
- Resistência à Meticilina
- Resistência a todos os beta-lactâmicos ( mutação PBP2A);
- Vancomicina - alternativa para tratar MRSA.

Qual das espécies de Staphylococcus é DNAse positiva?
S. aureus
Quais as espécies mais importantes de Staphylococcus?
S. aureus - mais importante e mais frequente;
S. epidermis; S. saprophyticus; S. haemolyticus; S. lugdunensis.
Testes de resistência e sensibilidade que permitem distinguir alguns Streptococcus de Staphylococcus?
NOVOBIOCINA: Staphylo saprophyticus é resistente; diferencia de outros staphylococcus
OPTOQUINA: Strepto. viridans é resistente;
BACITRACINA: Strepto. pyogenes é sensível.
Características de Staphylo aureus? (3)
- coagulase positivo
- DNAse positivo
- fermenta o manitol (torna o meio amarelo- dai chamar-se aureus -ouro)
Qual é a função da catalase
Proteção contra metabolitos tóxicos
Toxina do choque tóxico
TSST-1
Criança com febre, sem focos infecciosos, com bacteriémia positiva para S.Aureus
Osteomielite estafilococica
Síndromes mediados por enterotoxinas
- Síndrome pele escaldada - Endotoxina esfoliativa
- S. Choque tóxico - TSST-1
- Intoxicação alimentar - Enterotoxina A
Resultado do esfregaço cutâneo em caso de SSSS
(Staphylococcal Scalded Skin Syndrome (SSSS) ou Doença de Ritter)
Inútil, não se vão encontrar estafilococcus
Causado pelas toxinas exfoliativas (ET-A e ET-B)
Doente na UCI, estabilizado com colocação de acessos, que se terão mantido. 2-3 dias depois começa com febre
Bacteriémia por S.Epidermidis
Em que casos é que a cultura positiva para S.Epidermidis não é sinal de contaminação
Quando há presença de próteses
Mecanismo de resistência do Estafilo à Meticilina
mecA - gene de resistências que codifica para PB2A
Mutação PB2A (< Afinidade para os b-lactamicos)

Forma de transmissão da resistência à meticilina
Disseminação MRSA
Transferência horizontal do gene SCCmec (conjugação)


